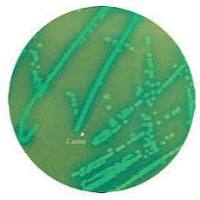
印度HiMedia 葡萄球菌选择性显色培养基

相关产品推荐更多 >
万千商家帮你免费找货
0 人在求购买到急需产品
- 详细信息
- 文献和实验
- 技术资料
- 保存条件:
2-8℃
- 保质期:
1年
- 英文名:
ECM (Endothelial Cell Medium)
- 库存:
100
- 供应商:
深圳子科生物科技有限公司
- 规格:
500 ml
Size/Quantity:500 ml
Product Use:This product is for research use only. It is not approved for use in humans, animals, or in vitro diagnostic procedures.
Storage:Store the basal medium at 4°C, the ECGS, the FBS and the P/Ssolution at -20°C. Protect from light.
Shipping Info:Basal medium: room temperature. Supplements: dry ice.
详细产品介绍和说明书、货期可以咨询在线客服,或者电话咨询:1392447706苏元元(微信同号)!
风险提示:丁香通仅作为第三方平台,为商家信息发布提供平台空间。用户咨询产品时请注意保护个人信息及财产安全,合理判断,谨慎选购商品,商家和用户对交易行为负责。对于医疗器械类产品,请先查证核实企业经营资质和医疗器械产品注册证情况。
文献和实验细胞培养的基本步骤都有哪些?复苏、传代、冻存的基本操作是什么样的?如果你刚刚开始细胞培养实验,想要建立稳定的细胞培养流程,快来听Dr. 赛的讲解吧。
人 内皮素 (ET) 酶联免疫分析 试剂盒使用说明书 本试剂仅供研究使用 目的:本试剂盒用于测定人血清,血浆及相关液体样本中 内皮素 (ET) 的含量。 实验原理: 本试剂盒应用双抗体夹心法测定标本中人 内皮素 (ET) 水平。用纯化的人 内皮素 (ET) 抗体包被微孔板,制成固相抗体,往包被单抗的微孔中依次加入 内皮素 (ET) , 再与 HRP 标记的 内皮素 (ET) 抗体结合,形成
[1]普遍存在于高等植物的茎、根、叶任何一部分的鞘状组织,一般作为皮层的最内层组织。内皮层常见于蕨类植物,在种子植物的根中一般也可见到,但茎和叶中则较为稀少。一般为一轮的外生内皮层( external endodermis),但常常在维管束的内方还存在一轮而成为双内皮层( double endoderm-is),偶而有成为每个维管束都各自单独一轮的独立内皮层( individual endodermis)。于木贼属( E-quisetum)中可见有两者之例。在径向壁和上下壁有线状目洗
技术资料暂无技术资料 索取技术资料